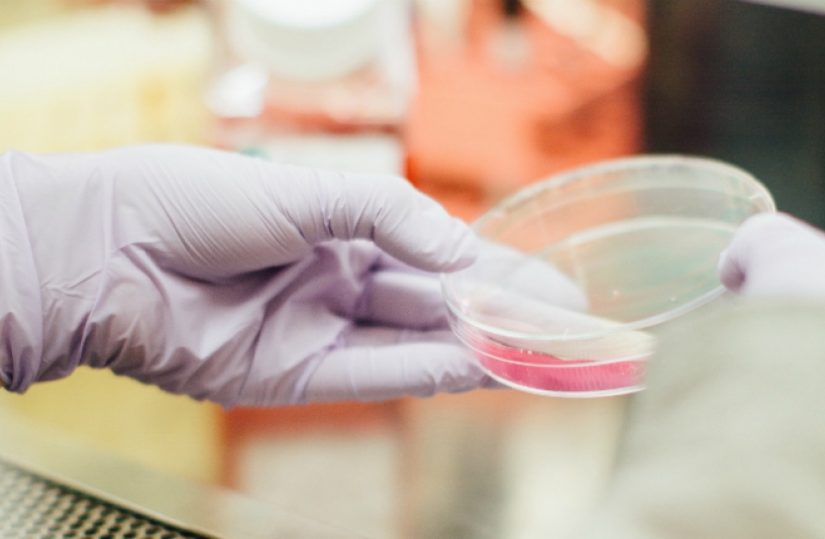

14 Mar 2019
Congresso Nacional da distribuição farmacêutica em abril
Focado na atividade da Distribuição Farmacêutica de Serviço Completo e no panorama atual da cadeia de distribuição do medicamento e...14 Mar 2019
Sociedade Portuguesa de Pneumologia deixa algumas recomendações para dormir melhor
Estes são dados de um questionário realizado online pela Sociedade Portuguesa de Pneumologia e pela Sociedade Portuguesa de Medicina do...14 Mar 2019
Congresso da Urgência Geral Polivalente CHULC
Este Congresso conta com o apoio da Associação Científica dos Enfermeiros (ACE) do CHULC. Entre outros, vão ser debatidos temas...14 Mar 2019
Congresso reúne especialistas nacionais e internacionais para debater a Anestesiologia
O encontro vai contar com a colaboração de especialistas nacionais e internacionais na área de Anestesiologia. O evento, organizado pela...14 Mar 2019
36.º ENMGF: APMGF e semFYC firmam parceria ibérica em prol da formação dos MF
Esta parceria entre Medicina Geral e Familiar (MGF) portuguesa e espanhola foi formalizada durante a cerimónia de abertura do 36.º...14 Mar 2019
36.º ENMGF: Médicos de família “na linha da frente” do desenvolvimento da especialidade
O médico de família e presidente da APMGF, Rui Nogueira, abriu os trabalhos, dando as boas-vindas aos colegas oriundos de...14 Mar 2019
Mais de 140 pessoas usufruíram de consultas de prescrição social em cinco meses
A dar os primeiros passos em Portugal, os projetos de prescrição Social visam ligar os utentes dos Cuidados de Saúde...14 Mar 2019
Visita aos novos equipamentos do Centro Hospitalar Lisboa Central
Os novos equipamentos – angiografia biplanar digital, ressonância magnética e sistema de biópsia prostática por fusão de imagem – traduzem...13 Mar 2019
“Novos desafios em Oncologia” em debate em Lisboa
Este evento reúne Radioncologistas de todo o país que vão trocar experiências sobre a mais inovadora tecnologia que existe no...13 Mar 2019
MSD Portugal lança Prémio de Investigação em Saúde
As candidaturas à 1ª Edição do Prémio MSD Investigação em Saúde decorrem de 15 de março a 30 de abril....13 Mar 2019
Mais de 1.960 doentes aguardavam transplante renal no final do ano passado
No primeiro semestre do ano passado foram realizados 235 transplantes renais, menos do que em igual período do ano anterior...13 Mar 2019
Travar a progressão da Doença de Parkinson está mais perto de ser uma realidade
“Sabemos hoje que há diferentes aglomerados de proteínas que se acumulam no cérebro dos doentes e estão associadas a patologias...13 Mar 2019
Visita às novas valências do Hospital de Santarém e inauguração da USF Beira Tejo em Abrantes
O investimento ascendeu a 350 mil euros. A visita vai permitir ainda avaliar o andamento dos trabalhos no novo Bloco...12 Mar 2019
Vacinómetro: Dados Finais da época gripal 2018/2019
A estes juntam-se os cerca de 240 mil cidadãos com idades entre os 60 e os 64 anos, também eles...12 Mar 2019
Portugal pode não atingir eliminação da Hepatite C até 2030
Este cálculo matemático é possível através da consulta da ferramenta inovadora Let’s End HepC (LEHC), desenvolvida pela Universidade Católica Portuguesa...12 Mar 2019